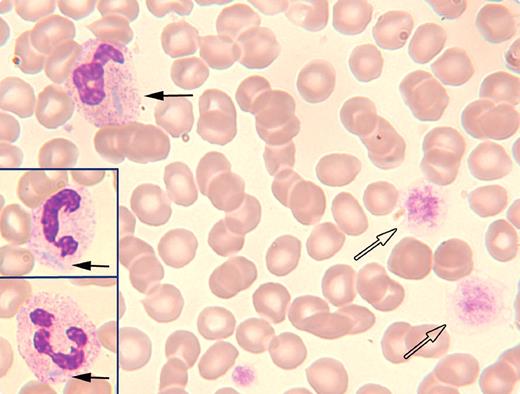

A 35-year-old woman with known May-Hegglin anomaly (and a positive family history) was seen in a fertility clinic. She was found to have marked thrombocytopenia (16 × 109/L). The other cell counts were normal. Other than hypothyroidism that was controlled with levothyroxine, she was otherwise healthy with no evidence of bleeding. The peripheral blood film demonstrated the features of May-Hegglin with megathrombocytes (open arrows) and neutrophils with prominent Döhle-like bodies (neutrophil and inset, solid black arrows). The actual platelet count was underestimated by the automated counter because of the abnormally large platelets. The peripheral smear suggested that the platelet count was higher and a more accurate calculation showed the platelet count to be 56 × 109/L.
May-Hegglin anomaly along with Sebastian syndrome, Fechtner syndrome, and Epstein syndrome are autosomal dominant genetic disorders involving mutations in the MYH9 gene encoding for the nonmuscle myosin heavy chain IIA (NMMHC-IIA). All of these entities are associated with macrothrombocytopenias, leukocyte inclusions (Döhle-like bodies), and variable clinical features of sensorineural hearing loss, cataracts, and renal failure. This case emphasizes the importance of the history and a review of the peripheral smear when abnormally large platelets give false readings on automated cell counters.
A 35-year-old woman with known May-Hegglin anomaly (and a positive family history) was seen in a fertility clinic. She was found to have marked thrombocytopenia (16 × 109/L). The other cell counts were normal. Other than hypothyroidism that was controlled with levothyroxine, she was otherwise healthy with no evidence of bleeding. The peripheral blood film demonstrated the features of May-Hegglin with megathrombocytes (open arrows) and neutrophils with prominent Döhle-like bodies (neutrophil and inset, solid black arrows). The actual platelet count was underestimated by the automated counter because of the abnormally large platelets. The peripheral smear suggested that the platelet count was higher and a more accurate calculation showed the platelet count to be 56 × 109/L.
May-Hegglin anomaly along with Sebastian syndrome, Fechtner syndrome, and Epstein syndrome are autosomal dominant genetic disorders involving mutations in the MYH9 gene encoding for the nonmuscle myosin heavy chain IIA (NMMHC-IIA). All of these entities are associated with macrothrombocytopenias, leukocyte inclusions (Döhle-like bodies), and variable clinical features of sensorineural hearing loss, cataracts, and renal failure. This case emphasizes the importance of the history and a review of the peripheral smear when abnormally large platelets give false readings on automated cell counters.
Many Blood Work images are provided by the ASH IMAGE BANK, a reference and teaching tool that is continually updated with new atlas images and images of case studies. For more information or to contribute to the Image Bank, visit http://imagebank.hematology.org.
This feature is available to Subscribers Only
Sign In or Create an Account Close Modal